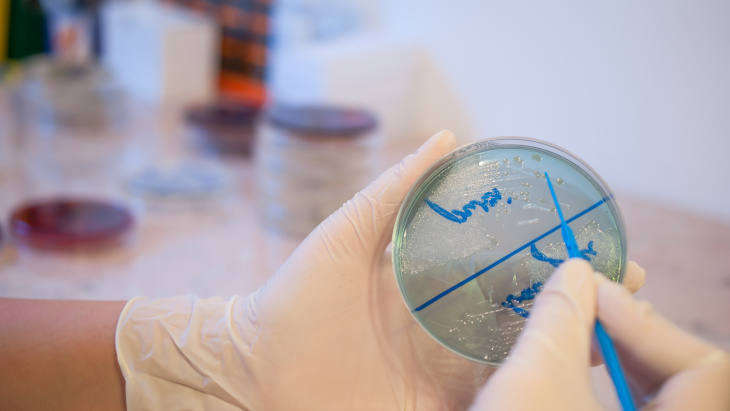
Rapport final du projet pilote de surveillance de l'antibiorésistance d’agents pathogènes pour les animaux

Rapport final du projet pilote de surveillance de l'antibiorésistance d’agents pathogènes pour les animaux
Date de publication :
C’est la première fois que des agents pathogènes pour les animaux font l’objet d’une surveillance en Suisse dans le cadre d’un projet pilote.
Les données présentées peuvent être considérées comme un premier état des lieux, même si elles ne sont pas totalement représentatives, dès lors que les laboratoires de diagnostic suisses n’ont pas tous fait parvenir des isolats.
Les données présentées peuvent être considérées comme un premier état des lieux, même si elles ne sont pas totalement représentatives, dès lors que les laboratoires de diagnostic suisses n’ont pas tous fait parvenir des isolats.
